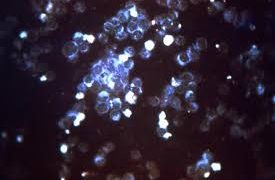

ウマ(馬)の病気
ウマ(馬)の病気 馬ヘルペスウイルス(Equine Herpesviruses) ~ 発熱、流産、呼吸器感染症、希に神経症状を発症させる伝染病
馬ヘルペスウイルス(EHV)は、二本鎖のDNAウイルスで、世界中で少なくとも9種類のウイルスが確認されています。EHVは、世界中の馬産業のあらゆる分野において、経済的にも福祉的にも大きな影響を与えています。他の種のヘルペスウイルスと同様に、...
 ウマ(馬)の病気
ウマ(馬)の病気  ウマ(馬)の病気
ウマ(馬)の病気 ウシ(牛)の病気
ウシ(牛)の病気  ウシ(牛)の病気
ウシ(牛)の病気